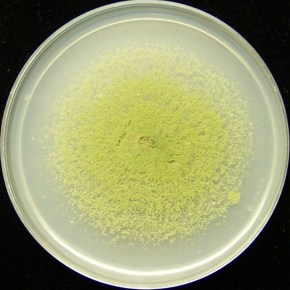
‘Bio-control’=effective control of aflatoxins poisoning Kenya’s staple food&nbsp;crops

A new report strengthens the economic case for increased public investment and other policy attention on food safety in developing countries. It synthesizes evidence of the economic costs of unsafe food in relation to both domestic markets and trade, positions food safety as an integral part of economic development and food system modernization, and provides guidance on improving food safety awareness and behaviour from farm to fork. Continue reading
Category Archives: Aflatoxins
Improving food safety and human health through agricultural research: CGIAR future plans
A useful summary of the future plans of the CGIAR Research Program on Agriculture for Nutrition and Health (A4NH), led by the International Food Policy Research Institute (IFPRI), based in Washington, DC, has been published. Two of the five flagships of this multi-institutional research program are led or co-led by the International Livestock Research Institute (ILRI), based in Nairobi, Kenya. Future work of these two flagships is described below. Continue reading
Aflatoxin levels in cow milk and feed in the Addis Ababa milk shed—New study
Ethiopian farmer with fresh milk from her cow (photo credit: ILRI/Apollo Habtamu). This article is written by ILRI scientists Dawit Gizachew, Barbara Szonyi, Azage Tegegne, Jean Hanson and Delia Grace Editor’s note: A statement in the article below, comparing various levels of risk, offended some of our readers. We thank those readers who let us … Continue reading
All flesh is grass (except in Nigeria, where it might be cassava peel)
Scientists are developing a way of transforming the mountains of cassava peels created every day in Nigeria, where cassava is a staple food, into a nourishing feed for smallholder farm animals. The several CGIAR centres involved include the International Livestock Research Institute (ILRI), the International Institute for Tropical Agriculture (IITA) and the International Potato Center (CIP). Also involved in this project are several CGIAR research programs—Livestock and Fish; Integrated Systems for the Humidtropics; and Roots, Tubers and Bananas—as well as the Global Cassava Partnership for the 21st Century (GCP21). Continue reading
Aflatoxins in Kenya’s food chain: Overview of what researchers are doing to combat the threat to public health
Aflatoxins are toxic chemicals produced as by-products by fungi (moulds) that grow on maize, groundnuts and other food crops. These toxins also affect feedstuffs, which then contaminate milk, meat and eggs. The toxins occur everywhere in the world, but pose particularly high risks in tropical developing countries where certain staple foods, such as maize and sorghum, comprise a large part of the diets of the poor. Continue reading
‘Bio-control’=effective control of aflatoxins poisoning Kenya’s staple food crops
Biocontrol is one way of managing aflatoxins by targeting the fungus that produces aflatoxin while the crop is still in the field. Continue reading
Dairy feed project to reduce aflatoxin contamination in Kenya’s milk
Mycotoxins, such as aflatoxin, are toxins found in food that can cause illness and be lethal in high doses. These toxins are formed by strains of moulds that infest susceptible grains such as maize and sorghum. Dairy cows that eat contaminated feed can yield contaminated milk. Milk is a major food in Kenya. Understanding how, … Continue reading
Australia-funded research fights aflatoxin contamination in East African foods
An Australian-funded program is giving scientists in East Africa tools and capacity to address the threat posed by aflatoxins to food safety and food security in the region. Continue reading